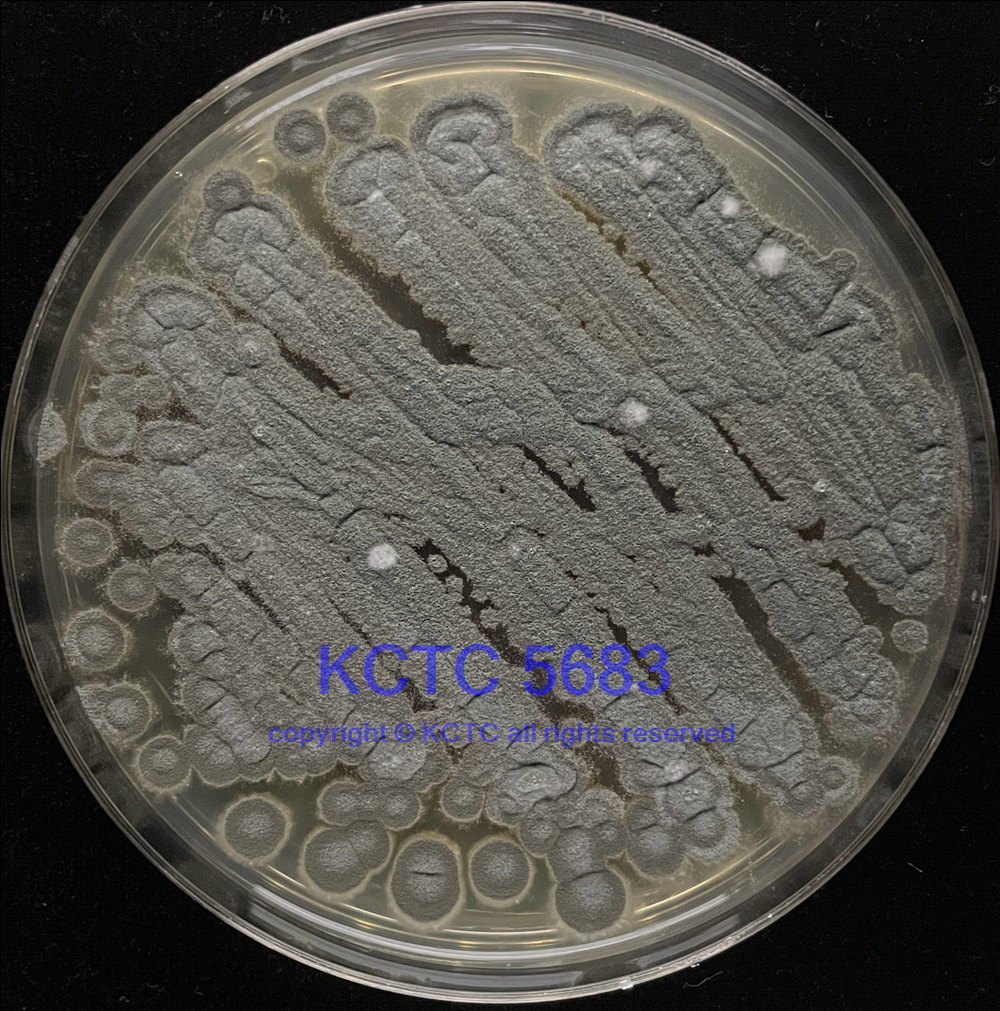

KCTC No. 5683
(KCTC Other No.)
Resource Type Bacteria
Name Prevotella nigrescens
Type Strain No
Biosafty Level 2
LMO No
Synonym
Phylum (ex Phylum) Bacteroidota (Bacteroidetes)
Genome Information
History <- Joong-Ki Kook, Chosun Univ., KCOM 1045 <- ChDC B288-II
Source From subgingival dental plaque, gingivitis, human
Other Collection No. ChDC B288-II, KCOM [1045]
Reference
KCTC Media No. KCTC media No. 753 Blood medium
Oxygen Requirement Anaerobic
Temperature 37 ℃
pH netural pH ?? ?? (???? ??)
Incubation Time